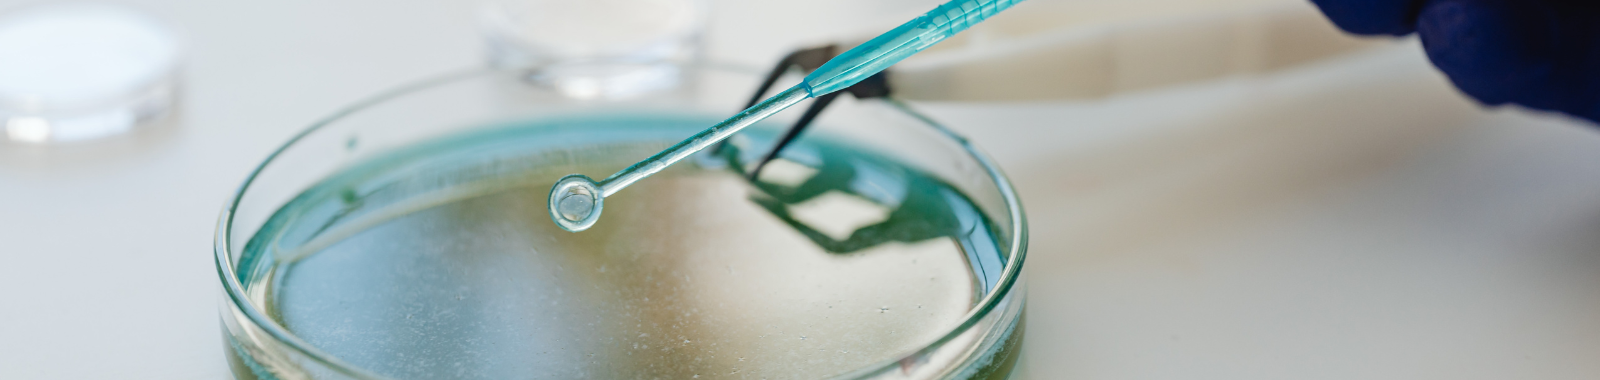

Food Testing
Testing for Life
61 Science Park Road, #05-03/08, The Galen, Singapore 117525
Eurofins Food Testing Singapore Pte Ltd is an ISO 17025 accredited laboratory located in Science Park 2, Singapore. We specialize in analysing infant formula, sole-source nutrition products, dietary supplements, and general food. Our testing portfolio includes vitamins, minerals, contaminants, pesticides, shelf-life studies and more.
At our state-of-the-art laboratory in Singapore, you benefit from our global capabilities being accessible locally. We specialize in nutritional and contaminant testing, providing innovative food testing solutions that help you mitigate risk and meet regulatory requirements.